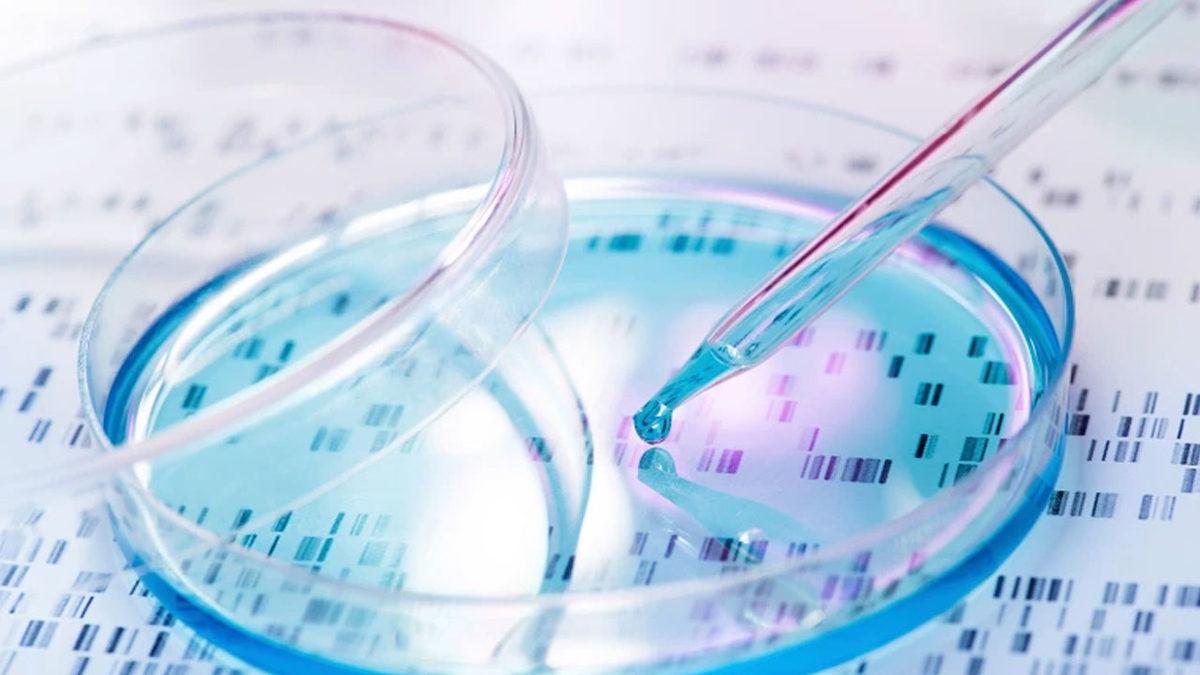
Bilim İnsanları, Gen Düzenleme Teknolojisi Kullanarak Yeni Bir Kanser Tedavisi Geliştirdi

Bilim dünyası kanserin ölümcül olduğunu tespit ettiği günden bugüne kadar kansere karşı mücadelesini sürdürmeye devam ediyor. Bu ölümcül hastalığa karşı pek çok önemli gelişme yaşandı ve yöntemler geliştirildi. Ancak her şeye rağmen kansere tamamen karşı gelebilen bir tedavi geliştirilemedi.
Tel Aviv Üniversitesi'ndeki bilim insanlarıysa bu konuda yeni bir ilerleme kaydetti. Yeni çalışmalarını Science Advances dergisinde yayınlayan bilim insanları, CRISPR gen düzenleme teknolojisinin yardımıyla bir yöntem geliştirdi. Bilim insanları, CRISPR'ın ölümcül kanseri ortadan kaldırma ihtimalinin olduğunu söyledi.
İçerikten Görseller
Kanser hücreleri yeniden aktif olmayacak şekilde öldürülüyor:
CRISPR, normal şartlarda potansiyel olarak zararlı genetik bozuklukları düzeltmek için geliştirilmişti. Ancak bilim insanları, yayınladıkları araştırmada bunun kansere karşı bir çare olabileceğini belirtti. Bilim insanları, 'yeni lipit nanopartikül bazlı dağılım sistemi' ismini verdikleri sistemle kanser hücrelerini hedef alabildiklerini ve bu hücreleri yeniden aktif olmayacak şekilde öldürebildiklerini açıkladı.
Yayınlanan makalede bilim insanlarının geliştirdikleri yeni sistemin nasıl çalıştığına da değinildi. Buna göre bilim insanları, basitçe anlatmak gerekirse nanopartikülleri kullanarak CRISPR enzimi olan Cas9'a mesaj gönderiyor ve enzime kanser hücrelerini hedef aldırıyordu. Aynı mesajda enzimden 'moleküler makas' olması ve hücrenin DNA'sını kesmesi isteniyordu.

Bilim insanları, sistemin en yüksek ölüm oranına sahip iki kanser türü olan glioblastoma ve metastatik yumurtalık kanserini hedef alarak kanıtlamaya çalıştı. Fareler üzerinde yapılan deneyde yeni CRISPR yönteminin hayatta kalma oranını iki katına çıkardığı görüldü. Üstelik bu yalnızca tek bir tedavinin verdiği sonuçtu.
Makalenin yazarlarından Profesör Dan Peer, yaptığı açıklamada bunun bir kemoterapi olmadığına, yan etkisinin bulunmadığına ve kanser hücresinin bir daha aktif olmayacak şekilde öldürüldüğüne dikkat çekti. Bilim insanları, ilerleyen dönemde CRISPR sisteminin diğer hastalıklar üzerindeki etkisini de inceleyecekler.
